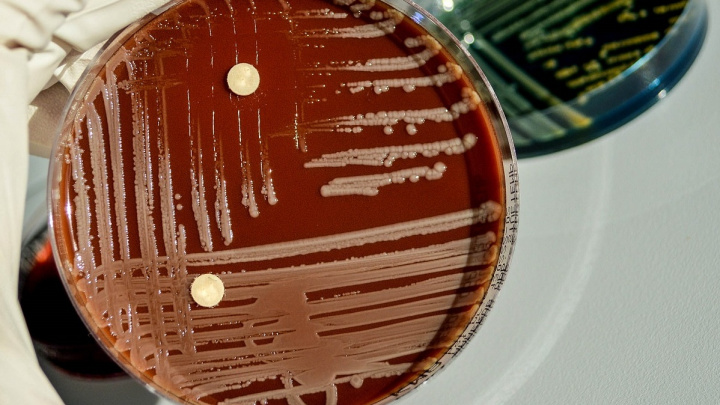

Články s tagem: Věda
Magazín
Trpí lidé, kteří rádi fotí sami sebe, narcismem?
21. 5. 2017
|
red
Proč lidé mají potřebu fotit sami sebe a sdílet to na internetu? Jsou zatím jen narcistické sklony, nebo to má i jiný důvod? Na to si posvítili vědci z americké Univerzity Brighama Younga.
Člověk
Středověcí vesničané zohavovali mrtvoly, báli se nemrtvých
19. 5. 2017
|
Ladislav Loukota
Pokud platí, že pohřbívání zesnulých je známkou vyspělosti kultury, středověká anglická vesnice Wharram Percy na severu hrabství Yorkshire si tu svou za rámeček zřejmě nedala. Zdejší nález polámaných, spálených či jinak zohavených lidských těl objevených v pohřební jámě přesto vypovídá mnoho o někdejších venkovských zvycích.
Člověk
Češi přišli na nový způsob výroby antibiotik. Mají být mnohem účinnější
18. 5. 2017
|
šar
Vědci z výzkumného centra Biocev objevili nový způsob výroby antibiotik, která by měla mít několikanásobně vyšší účinek. Některá by měla dobře zabírat například i proti malárii. Nové látky si nechali patentovat a zahájili rozsáhlé testování. K medicínsky použitelnému léčivu bude ale podle Evy Jurkové z Akademie věd ČR potřeba ještě mnoho let práce.
Člověk
Jurský park s opicemi: Nalezena fosilie krve prastarých savců
17. 5. 2017
|
Ladislav Loukota
Skoro jako z Jurského parku působí nález fosilizovaných červených krvinek patřících opičím předchůdcům člověka z doby před 20 až 30 miliony let. Zkamenělou životodárnou tekutinu totiž vědci nalezli v klíštěti archivovaném uvnitř jantaru. Detailní analýza krve však překovala příběh alternativní verze Jurského parku v horor. Uvnitř vzorku totiž vědci našly stopy ještě něčeho ještě překvapivějšího – nejstarší dochovanou fosilii buněčných parazitů.
Člověk
Party droga jako antidepresivum: Vědci začínají chápat, jak skutečně účinkuje
16. 5. 2017
|
Jan Toman
Ketamin je chemickou látkou s dlouhou, pohnutou a nesmírně zajímavou historií. Farmakologové ho prvně syntetizovali v 60. letech 20. století jako anestetikum nového typu. Postupně vystřídal roli prostředku k vyřazení vědomí, léku tlumícího bolest, rekreační drogy, nástroje psychologického výzkumu a poněkud překvapivě také antidepresiva. Ve všech oblastech své aplikace přinesl větší či menší revoluci. A to přesto, že dodnes není zcela jasné, jaké funkce mozku a jakými cestami vlastně ovlivňuje.
Člověk
Srdce ze špenátu: Vědci využili rostlinu k 'výrobě' srdeční tkáně
15. 5. 2017
|
Ladislav Loukota
Ačkoliv moderní medicína už pomalu dosáhla na tvorbu umělých tkání, to nejlepší, co z 3D tisku v medicíně v dohledné době dorazí, bude umělá kůže určená pro oběti popálenin. Komplexnější tkáně jako orgány jsou však stejně vzdálené jako desetiletí nazpět.
Vesmír
NASA by ráda vybudovala bránu do hlubokého vesmíru. Jak je na tom?
12. 5. 2017
|
Ladislav Loukota
Obrysy budoucí stanice Deep Space Gateway se již rýsují – mnozí si však myslí, že zůstane jen u nich. Ve výběrovém řízení o budoucí stanici NASA přitom nejde o málo. Kromě mnohamiliardové zakázky pro vítěze by stanice v hlubokém vesmíru měla být především modelem pro kosmickou loď pro let k Marsu a dále.
Příroda
Padla další bariéra mezi lidmi a zvířaty: Holubi hromadí kulturní poznatky
11. 5. 2017
|
Jan Toman
Čím lépe poznáváme vlastní druh a ostatní zástupce živočišné říše, tím více se v naších očích rozdíly mezi člověkem a zvířaty stírají. Pokročilé systémy komunikace, kultura nebo používání nástrojů byly kdysi považovány za ryze lidské vlastnosti. Ovšem jen do doby, než ptáci, kytovci, potkani, lidoopi a další živočišné skupiny rázně nakoply naše druhové ego.